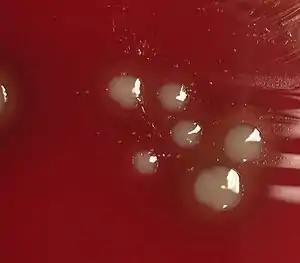

Haemophilus influenzae
Haemophilus influenzae (formerly called Pfeiffer's bacillus or Bacillus influenzae) is a Gram-negative, coccobacillary, facultatively anaerobic capnophilic pathogenic bacterium of the family Pasteurellaceae. H. influenzae was first described in 1892 by Richard Pfeiffer during an influenza pandemic.[1] He incorrectly described Haemophilus influenzae as the causative microbe, which retains "influenza" in its name.[2][3]
| Haemophilus influenzae | |
|---|---|
 | |
| H. influenzae on a chocolate agar plate | |
| Scientific classification | |
| Domain: | Bacteria |
| Phylum: | Pseudomonadota |
| Class: | Gammaproteobacteria |
| Order: | Pasteurellales |
| Family: | Pasteurellaceae |
| Genus: | Haemophilus |
| Species: | H. influenzae |
| Binomial name | |
| Haemophilus influenzae (Lehmann & Neumann 1896) Winslow et al. 1917 | |
| Haemophilus influenzae infection | |
|---|---|
| |
| Haemophilus influenzae satellite colonies (pin points) near Staphylococcus aureus (yellow) on blood agar plate | |
| Specialty | Infectious disease |
The bacterium was argued by some to be the cause of influenza[4] as bacterial influenza. H. influenzae is responsible for a wide range of localized and invasive infections, but influenza is caused by viruses.
This species was the first free-living organism to have its entire genome sequenced.[5]
Serotypes
In 1930, two major categories of H. influenzae were defined: the unencapsulated strains and the encapsulated strains. Encapsulated strains were classified on the basis of their distinct capsular antigens. The six generally recognized types of encapsulated H. influenzae are: a, b, c, d, e, and f.[6] Genetic diversity among unencapsulated strains is greater than within the encapsulated group. Unencapsulated strains are termed nontypable (NTHi) because they lack capsular serotypes; however, they can be classified by multilocus sequence typing. The pathogenesis of H. influenzae infections is not completely understood, although the presence of the polyribosyl ribitol phosphate (PRP) capsule in encapsulated type b (Hib), a serotype causing conditions such as epiglottitis, is known to be a major factor in virulence.[7] Their capsule allows them to resist phagocytosis and complement-mediated lysis in the nonimmune host. The unencapsulated strains are almost always less invasive; they can, however, produce an inflammatory response in humans, which can lead to many symptoms. Vaccination with Hib conjugate vaccine is effective in preventing Hib infection but does not prevent infection with NTHi strains.[8]
Most strains of H. influenzae are opportunistic pathogens; that is, they usually live in their host without causing disease, but cause problems only when other factors (such as a viral infection, reduced immune function or chronically inflamed tissues, e.g. from allergies) create an opportunity. They infect the host by sticking to the host cell using trimeric autotransporter adhesins.[9]
Haemophilus influenzae type b (Hib) infection
Naturally acquired disease caused by H. influenzae seems to occur in humans only. In infants and young children, H. influenzae type b (Hib) causes bacteremia, pneumonia, epiglottitis and acute bacterial meningitis.[10] On occasion, it causes cellulitis, osteomyelitis, and infectious arthritis. It is one cause of neonatal infection.[11]
Due to routine use of the Hib vaccine in the U.S. since 1990, the incidence of invasive Hib disease has decreased to 1.3/100,000 in children.[10] However, Hib remains a major cause of lower respiratory tract infections in infants and children in developing countries where the vaccine is not widely used. Unencapsulated H. influenzae strains are unaffected by the Hib vaccine and cause ear infections (otitis media), eye infections (conjunctivitis), and sinusitis in children, and are associated with pneumonia.[10]
Diagnosis



Clinical features may include initial symptoms of an upper respiratory tract infection mimicking a viral infection, usually associated with fevers, often low-grade. This may progress to the lower respiratory tract in a few days, with features often resembling those of wheezy bronchitis. Sputum may be difficult to expectorate and is often grey or creamy in color. The cough may persist for weeks without appropriate treatment. Many cases are diagnosed after presenting chest infections that do not respond to penicillins or first-generation cephalosporins. A chest X-ray can identify alveolar consolidation.[12]
Clinical diagnosis of H. influenzae is typically performed by bacterial culture or latex particle agglutinations. Diagnosis is considered confirmed when the organism is isolated from a sterile body site. In this respect, H. influenzae cultured from the nasopharyngeal cavity or sputum would not indicate H. influenzae disease, because these sites are colonized in disease-free individuals.[13] However, H. influenzae isolated from cerebrospinal fluid or blood would indicate H. influenzae infection.
Culture
Bacterial culture of H. influenzae is performed on agar plates, the preferable one being chocolate agar, with added X (hemin) and V (nicotinamide adenine dinucleotide) factors at 37 °C in a CO2-enriched incubator.[14] Blood agar growth is only achieved as a satellite phenomenon around other bacteria. Colonies of H. influenzae appear as convex, smooth, pale, grey, or transparent colonies.
Gram stained and microscopic observation of a specimen of H. influenzae will show Gram-negative coccobacillus. The cultured organism can be further characterized using catalase and oxidase tests, both of which should be positive. Further serological testing is necessary to distinguish the capsular polysaccharide and differentiate between H. influenzae b and nonencapsulated species.
Although highly specific, bacterial culture of H. influenzae lacks sensitivity. Use of antibiotics prior to sample collection greatly reduces the isolation rate by killing the bacteria before identification is possible.[15] Beyond this, H. influenzae is a finicky bacterium to culture, and any modification of culture procedures can greatly reduce isolation rates. Poor quality of laboratories in developing countries has resulted in poor isolation rates of H. influenzae.. Recent work has shown that H.influenzae uses a highly specialised spectrum of nutrients where lactate is a preferred carbon source.[16]
H. influenzae will grow in the hemolytic zone of Staphylococcus aureus on blood agar plates; the hemolysis of cells by S. aureus releases factor V which is needed for its growth. H. influenzae will not grow outside the hemolytic zone of S. aureus due to the lack of nutrients such as factor V in these areas. Fildes agar is best for isolation. In Levinthal medium, capsulated strains show distinctive iridescence.
Latex particle agglutination
The latex particle agglutination test (LAT) is a more sensitive method to detect H. influenzae than is culture.[17] Because the method relies on antigen rather than viable bacteria, the results are not disrupted by prior antibiotic use. It also has the added benefit of being much quicker than culture methods. However, antibiotic sensitivity testing is not possible with LAT alone, so a parallel culture is necessary.
Molecular methods
Polymerase chain reaction (PCR) assays have been proven to be more sensitive than either LAT or culture tests, and highly specific.[17] However, PCR assays have not yet become routine in clinical settings. Countercurrent immunoelectrophoresis has been shown to be an effective research diagnostic method but has been largely supplanted by PCR.
Interaction with Streptococcus pneumoniae
Both H. influenzae and S. pneumoniae can be found in the upper respiratory system of humans. In an in vitro study of competition, S. pneumoniae always overpowered H. influenzae by attacking it with hydrogen peroxide and stripping off the surface molecules H. influenzae needs for survival.[18]
When both bacteria are placed together into a nasal cavity, within two weeks, only H. influenzae survives. When either is placed separately into a nasal cavity, each one survives. Upon examining the upper respiratory tissue from mice exposed to both bacteria species, an extraordinarily large number of neutrophils (immune cells) was found. In mice exposed to only one of the species, the neutrophils were not present.
Lab tests showed neutrophils exposed to dead H. influenzae were more aggressive in attacking S. pneumoniae than unexposed neutrophils. Exposure to dead H. influenzae had no effect on live H. influenzae.
Two scenarios may be responsible for this response:
- When H. influenzae is attacked by S. pneumoniae, it signals the immune system to attack the S. pneumoniae
- The combination of the two species triggers an immune system response that is not set off by either species individually.
It is unclear why H. influenzae is not affected by the immune response.[19]
Disease
Haemophilus influenzae can cause respiratory tract infections including pneumonia, otitis media, epiglottitis (swelling in the throat), eye infections and bloodstream infection, meningitis. It can also cause cellulitis (skin infection) and infectious arthritis (inflammation of the joint).[20]
Treatment
Haemophilus influenzae produces beta-lactamases, and it is also able to modify its penicillin-binding proteins, so it has gained resistance to the penicillin family of antibiotics. In severe cases, cefotaxime and ceftriaxone delivered directly into the bloodstream are the elected antibiotics, and, for the less severe cases, an association of ampicillin and sulbactam, cephalosporins of the second and third generation, or fluoroquinolones are preferred. (Fluoroquinolone-resistant Haemophilus influenzae have been observed.)[21]
Macrolides and fluoroquinolones have activity against non-typeable H. influenzae and could be used in patients with a history of allergy to beta-lactam antibiotics.[22] However, macrolide resistance has also been observed.[23]
Serious and chronic complications
The serious complications of HiB are brain damage, hearing loss, and even death. This is commonly associated with HiB but however the Hi non-typable doesn't often cause serious conditions but it has more risks to a chronic infection because it has the ability to change its surface antigens. Chronic infections are usually not as serious than acute infections. [24]
Prevention

Effective vaccines for Haemophilus influenzae Type B have been available since the early 1990s, and are recommended for children under age 5 and asplenic patients. The World Health Organization recommends a pentavalent vaccine, combining vaccines against diphtheria, tetanus, pertussis, hepatitis B and Hib. There is not yet sufficient evidence on how effective this pentavalent vaccine is in relation to the individual vaccines.[25]
Hib vaccines cost about seven times the total cost of vaccines against measles, polio, tuberculosis, diphtheria, tetanus, and pertussis. Consequently, whereas 92% of the populations of developed countries were vaccinated against Hib as of 2003, vaccination coverage was 42% for developing countries, and only 8% for least-developed countries.[26]
The Hib vaccines do not provide cross-protection to any other Haemophilus influenzae serotypes like Hia, Hic, Hid, Hie or Hif.[27]
An oral vaccination has been developed for non-typeable Haemophilus influenzae (NTHi) for patients with chronic bronchitis but it has not shown to be effective in reducing the number and severity of COPD exacerbations.[28] However, there is no effective vaccine for the other types of capsulated Haemophilus inflenzae or Haemophilus inflenzae nontypeable.
Sequencing
H. influenzae was the first free-living organism to have its entire genome sequenced. Completed by Craig Venter and his team at The Institute for Genomic Research, one of the institutes now part of the J. Craig Venter Institute. Haemophilus was chosen because one of the project leaders, Nobel laureate Hamilton Smith, had been working on it for decades and was able to provide high-quality DNA libraries. The genome of strain Rd KW20 consists of 1,830,138 base pairs of DNA in a single circular chromosome that contains 1604 protein-coding genes, 117 pseudogenes, 57 tRNA genes, and 23 other RNA genes.[29] The sequencing method used was whole-genome shotgun, which was completed and published in Science in 1995.[30]
Likely protective role of transformation
Unencapsulated H. influenzae is often observed in the airways of patients with chronic obstructive pulmonary disease (COPD). Neutrophils are also observed in large numbers in sputum from patients with COPD. The neutrophils phagocytize H. influenzae, thereby activating an oxidative respiratory burst.[31] However instead of killing the bacteria the neutrophils are themselves killed (though such an oxidative burst likely causes DNA damage in the H. influenzae cells). Dearth of killing the bacteria appears to explain the persistence of infection in COPD.[31]
H. influenzae mutants defective in the rec1 gene (a homolog of recA) are very sensitive to killing by the oxidizing agent hydrogen peroxide.[32] This finding suggests that rec1 expression is important for H. influenzae survival under conditions of oxidative stress. Since it is a homolog of recA, rec1 likely plays a key role in recombinational repair of DNA damage. Thus H. influenzae may protect its genome against the reactive oxygen species produced by the host's phagocytic cells through recombinational repair of oxidative DNA damages.[33] Recombinational repair of a damaged site of a chromosome requires, in addition to rec1, a second homologous undamaged DNA molecule. Individual H. influenzae cells are capable of taking up homologous DNA from other cells by the process of transformation. Transformation in H. influenzae involves at least 15 gene products,[30] and is likely an adaptation for repairing DNA damage in the resident chromosome.
Vaccines that target unencapsulated H. influenzae serotypes are in development.[34]
See also
References
- Kuhnert, P; Christensen, H, eds. (2008). Pasteurellaceae: Biology, Genomics and Molecular Aspects. Caister Academic Press. ISBN 978-1-904455-34-9.
- Morens DM, Taubenberger JK, Folkers GK, Fauci AS (15 December 2010). "Pandemic influenza's 500th anniversary". Clinical Infectious Diseases. 51 (12): 1442–1444. doi:10.1086/657429. PMC 3106245. PMID 21067353.
- Taubenberger JK, Hultin JV, Morens DM (2007). "Discovery and characterization of the 1918 pandemic influenza virus in historical context". Antiviral Therapy. 12 (4 Pt B): 581–591. PMC 2391305. PMID 17944266.
- Soper, G. A. (1919-05-30). "The Lessons of the Pandemic". Science. 49 (1274): 501–506. Bibcode:1919Sci....49..501S. doi:10.1126/science.49.1274.501. ISSN 0036-8075. PMID 17793800.
- About the J. Craig Venter Institute, J. Craig Venter Institute website, retrieved November 21, 2015
- Ryan, KJ; Ray, CG, eds. (2004). Sherris Medical Microbiology (4th ed.). McGraw Hill. pp. 396–401. ISBN 978-0-8385-8529-0.
- "What is Haemophilus influenzae?".
- Slack, MP; et al. (1998). "Enhanced surveillance of invasive Haemophilus influenzae disease in England, 1990 to 1996: impact of conjugate vaccines". Pediatr Infect Dis J. 17 (9 suppl): S204–7. doi:10.1097/00006454-199809001-00026. PMID 9781764.
- "Haemophilus influenzae Disease (Including Hib)". Centers For Disease Control And Prevention. 18 March 2021. Retrieved 20 July 2021.
- "Epiglottitis". The Lecturio Medical Concept Library. 22 June 2020. Retrieved 20 July 2021.
- Baucells, B.J.; Mercadal Hally, M.; Álvarez Sánchez, A.T.; Figueras Aloy, J. (2015). "Asociaciones de probióticos para la prevención de la enterocolitis necrosante y la reducción de la sepsis tardía y la mortalidad neonatal en recién nacidos pretérmino de menos de 1.500g: una revisión sistemática". Anales de Pediatría. 85 (5): 247–255. doi:10.1016/j.anpedi.2015.07.038. ISSN 1695-4033. PMID 26611880.
- "Measuring impact of Streptococcus pneumoniae and Haemophilus influenzae type b conjugate vaccination" (PDF). World Health Organization. September 2012
- Puri J; Talwar V; Juneja M; Agarwal KN; et al. (1999). "Prevalence of antimicrobial resistance among respiratory isolates of Haemophilus influenzae". Indian Pediatr. 36 (10): 1029–32. PMID 10745313.
- Levine OS; Schuchat A; Schwartz B; Wenger JD; Elliott J; Centers for Disease Control (1997). "Generic protocol for population-based surveillance of Haemophilus influenzae type B" (PDF). World Health Organization. WHO/VRD/GEN/95.05. Archived from the original (PDF) on July 1, 2004.
- John TJ; Cherian T; Steinhoff MC; Simoes EA; et al. (1991). "Etiology of acute respiratory infections in children in tropical southern India". Rev Infect Dis. 13: Suppl 6:S463–9. doi:10.1093/clinids/13.supplement_6.s463. PMID 1862277.
- Hosmer, Jennifer; Nasreen, Marufa; Dhouib, Rabeb; Essilfie, Ama-Tawiah; Schirra, Horst Joachim; Henningham, Anna; Fantino, Emmanuelle; Sly, Peter; McEwan, Alastair G.; Kappler, Ulrike (2022-01-27). "Access to highly specialized growth substrates and production of epithelial immunomodulatory metabolites determine survival of Haemophilus influenzae in human airway epithelial cells". PLOS Pathogens. 18 (1): e1010209. doi:10.1371/journal.ppat.1010209. ISSN 1553-7374. PMC 8794153. PMID 35085362.
- Kennedy WA, Chang SJ, Purdy K, LE T, et al. (2007). "Incidence of bacterial meningitis in Asia using enhanced CSF testing: polymerase chain reaction, latex agglutination and culture". Epidemiol Infect. 135 (7): 1217–26. doi:10.1017/S0950268806007734. PMC 2870670. PMID 17274856.
- Pericone, Christopher D.; Overweg, Karin; Hermans, Peter W. M.; Weiser, Jeffrey N. (2000). "Inhibitory and Bactericidal Effects of Hydrogen Peroxide Production by Streptococcus pneumoniae on Other Inhabitants of the Upper Respiratory Tract". Infect Immun. 68 (7): 3990–3997. doi:10.1128/IAI.68.7.3990-3997.2000. PMC 101678. PMID 10858213.
- Lysenko E; Ratner A; Nelson A; Weiser J (2005). "The role of innate immune responses in the outcome of interspecies competition for colonization of mucosal surfaces". PLOS Pathog. 1 (1): e1. doi:10.1371/journal.ppat.0010001. PMC 1238736. PMID 16201010.
- "Signs and Symptoms". Centers for Disease Control and Prevention (CDC). 2019-01-24.
- Chang CM; Lauderdale TL; Lee HC; et al. (August 2010). "Colonisation of fluoroquinolone-resistant Haemophilus influenzae among nursing home residents in southern Taiwan". J. Hosp. Infect. 75 (4): 304–8. doi:10.1016/j.jhin.2009.12.020. PMID 20356651.
- Murphy, Timothy F. (2020). "Haemophilus Species, Including H. influenzae and H. ducreyi (Chancroid)". Mandell, Douglas, and Bennett's Principles and Practice of Infectious Diseases (9th ed.). Philadelphia, PA: Elsevier. ISBN 978-0-323-48255-4.
- Roberts MC; Soge OO; No DB (January 2011). "Characterization of macrolide resistance genes in Haemophilus influenzae isolated from children with cystic fibrosis". J. Antimicrob. Chemother. 66 (1): 100–4. doi:10.1093/jac/dkq425. PMID 21081549.
- "Serious Complications-CDC website". www.cdc.gov.
- Bar-On ES; Goldberg E; Hellmann S; Leibovici L (2012). "Combined DTP-HBV-HIB vaccine versus separately administered DTP-HBV and HIB vaccines for primary prevention of diphtheria, tetanus, pertussis, hepatitis B, and Haemophilus influenzae B (HIB)". Cochrane Database Syst Rev. 4 (4): CD005530. doi:10.1002/14651858.CD005530.pub3. PMID 22513932.
- "Haemophilus influenzae type B (HiB)". Health Topics A to Z. Retrieved 2011-03-29.
- Jin Z, Romero-Steiner S, Carlone GM, Robbins JB, Schneerson R (2007). "Haemophilus influenzae Type a Infection and Its Prevention". Infect. Immun. 75 (6): 2650–4. doi:10.1128/IAI.01774-06. PMC 1932902. PMID 17353280.
- Teo, Edward; Lockhart, Kathleen; Purchuri, Sai Navya; Pushparajah, Jennifer; Cripps, Allan W.; van Driel, Mieke L. (June 19, 2017). "Haemophilus influenzae oral vaccination for preventing acute exacerbations of chronic bronchitis and chronic obstructive pulmonary disease". The Cochrane Database of Systematic Reviews. 2017 (6): CD010010. doi:10.1002/14651858.CD010010.pub3. ISSN 1469-493X. PMC 6481520. PMID 28626902.
- "Haemophilus influenzae Rd KW20, complete sequence". 2020-04-04.
{{cite journal}}: Cite journal requires|journal=(help) - Fleischmann R; Adams M; White O; Clayton R; et al. (1995). "Whole-genome random sequencing and assembly of Haemophilus influenzae Rd". Science. 269 (5223): 496–512. Bibcode:1995Sci...269..496F. doi:10.1126/science.7542800. PMID 7542800. S2CID 10423613.
- Naylor EJ; Bakstad D; Biffen M; et al. (August 2007). "Haemophilus influenzae induces neutrophil necrosis: a role in chronic obstructive pulmonary disease?". Am. J. Respir. Cell Mol. Biol. 37 (2): 135–43. doi:10.1165/rcmb.2006-0375OC. PMID 17363778.
- Sánchez-Rincón DA; Cabrera-Juárez E (October 1991). "Lethal and mutagenic action of hydrogen peroxide on Haemophilus influenzae". J. Bacteriol. 173 (20): 6632–4. doi:10.1128/jb.173.20.6632-6634.1991. PMC 209002. PMID 1917884.
- Michod RE; Bernstein H; Nedelcu AM (May 2008). "Adaptive value of sex in microbial pathogens". Infect. Genet. Evol. 8 (3): 267–85. doi:10.1016/j.meegid.2008.01.002. PMID 18295550.} As PDF
- "A Study to Evaluate the Safety, Reactogenicity and Immunogenicity of GlaxoSmithkline (GSK) Biologicals' Investigational Vaccine GSK2838504A When Administered to Chronic Obstructive Pulmonary Disease (COPD) Patients With Persistent Airflow Obstruction". ClinicalTrials.gov. 2014-02-27. Retrieved 2016-09-20.
External links
| Wikimedia Commons has media related to Haemophilus influenzae. |
- Hib information on the World Health Organization (WHO) site.
- Fact sheet on the Centers for Disease Control and Prevention (CDC) site.
- Hib Initiative—from Johns Hopkins University, London School of Hygiene & Tropical Medicine, CDC & WHO
- November 2nd: World Pneumonia Day Website
- Centers for Disease Control and Prevention (2012). "Ch. 7: Haemophilus influenzae". In Atkinson W; Wolfe S; Hamborsky J (eds.). Epidemiology and Prevention of Vaccine-Preventable Diseases (12th ed.). Washington, D.C.: Public Health Foundation. pp. 87–100. Archived from the original on 2017-03-10.
- "Haemophilus influenzae". NCBI Taxonomy Browser. 727.
- Type strain of Haemophilus influenzae at BacDive – the Bacterial Diversity Metadatabase
